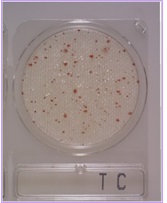
COMPACT DRY tc

Garantice la Seguridad de sus Aguas Cosméticas con COSMETIKIT-WATER
El kit COSMETIKIT-WATER es su solución esencial para un análisis microbiológico preciso, asegurando que las aguas que utiliza en la fabricación de sus productos cosméticos cumplen con los más altos estándares de calidad y seguridad.
1. Detección de Patógenos Clave (Enterococos fecales, Pseudomonas aeruginosa y Burkholderia cepacia)
Este paso es crucial para identificar la presencia de microorganismos peligrosos que podrían comprometer sus productos y la salud del consumidor.
Procedimiento:
- Añada 100 ml del agua de muestra en cada uno de los tres frascos de prueba (RPL301, RPL302 y RPL323). Importante: No llene completamente para dejar una cámara de aire.
- Agite suavemente para asegurar que el contenido concentrado se disuelva correctamente.
- Cierre el tapón e incube los frascos sin enroscar el tapón durante 18-72 horas a una temperatura de 35-37 ºC
Interpretación de Resultados:
- Enterococos (Contaminación Fecal): Si el frasco ámbar (con menisco azul) se vuelve completamente negro y pierde su iridiscencia (ver Fig. 1, izquierda), esto indica la presencia de contaminación fecal, probablemente por infiltración de aguas residuales.
- Pseudomonas aeruginosa: Si el frasco incoloro se vuelve de color rosa o rojizo (ver Fig. 2, izquierda).
- Burkholderia cepacia: Si el frasco anaranjado se vuelve de un intenso color rojo vino tinto (ver Fig. 3, izquierda).
Criterio de Uso:
La detección de cualquiera de estos microorganismos hace que el agua sea NO APTA para su uso en la fabricación de productos cosméticos.
Disposición Segura: Por favor, añada cloro o lejía hasta el borde de los botes usados o autoclávelos antes de desecharlos, para garantizar una eliminación segura y estéril.
2. Recuento General de Microorganismos Aerobios (Control de Calidad)
Este ensayo mide la cantidad total de bacterias presentes, un indicador fundamental de la higiene y calidad del agua.
Procedimiento:
- Usando una pipeta estéril, añada 1 ml del agua de muestra justo en el centro de una placa Dry-Plates®-TC Water.
- Deje que el medio deshidratado se absorba completamente y cierre la placa.
- Repita este proceso con una segunda placa Dry-Plates®-TC Water.
- Incubación:
- Incube la primera placa durante 24 horas a aprox 35 ºC (para aerobios mesófilos).
- Incube la segunda placa durante 72 horas a aprox 22 ºC (para aerobios psicrótrofos/contaminantes ambientales).
- Recuento: Cuente todas las colonias que aparezcan. Gracias al componente TTC, crecerán en una gama de colores que va del rosa al rojo (ver Fig. 4).
Criterio de Aceptación (Agua Apta):
Para que el agua se considere de calidad y apta para uso cosmético, debe cumplir estos dos criterios:
- Placa Dry-Plates®-TC Water de 1 día a 35°C: Menos de 20 colonias.
- Placa Dry-Plates®-TC Water de 3 días a 22°C: Menos de 100 colonias.
ANEXO FOTOGRÁFICO
Fig 1: Izda positivo de Enterococos fecales (negro), dcha negativo (ámbar)
En la Fig 2: Izda positivo de Pseudomonas aeruginosa (rosa), dcha negativo (paja)
Fig 3: Izda positivo de Burkholderia cepacia (tinto), dcha negativo (naranja)
En la Fig. 4: La DryPlates-TC Water a 22ºC muestra una contaminación superior a las 100 colonias, indicando un agua no apta.
https://www.microkit.es/pdf/COSMETIKIT-Water.pdf
Para consultas o precios actualizados sobre este o cualquier otro producto MICROKIT no dude en ponerse en contacto con nosotros en el teléfono 91-897 46 16 o en el correo electrónico microkit@microkit.es